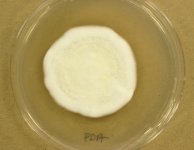

Search Details
| UAMH Number: | 5704 |
|---|---|
| Species Name: | Apinisia queenslandica |
| Type: | Brunneospora reticulata |
| Synonyms: | Amauroascus queenslandicus / Uncinocarpus queenslandicus |
| Taxonomy: | FUNGI Ascomycota, Eurotiomycetes, Onygenales, Onygenaceae |
| Strain History: | Guarro, J. (FMR 784) -> UAMH |
| Substrate: | arable soil | Location: | SPAIN Segria (GEO: 41.52,0.526) |
| Isolator: | |
| Isolation Date: | 1980-09-01 |
| Date Received: | 1987-03-16 |
| Characters: | MOLECULAR SYSTEMATICS Blast match 98% ITS similarity with Uncinocarpus queenslandicum - fide UAMH 2012 // SYSTEMATICS/ TAXONOMY revision of Uncinocarpus - Sigler et al., Can. J. Bot. 76:1624-1636, 1998 // THERMOTOLERANT growth equivalent at 30 & 35C - // THERMOTOLERANT opt. 37C - // THERMOTOLERANT revision of Uncinocarpus - Sigler et al., Can. J. Bot. 76:1624-1636, 1998 (Click for publications citing UAMH 5704) |
| Compounds: | |
| Cross Reference: | FMR 784 // IMI 315744 // IMI 315799 // UAMH 9130 |
| Collections: | Living Strains; Dried Herbarium Material |
| Pathogenic Potential: | Human: no | Animal: no | Plant: no |
| Biosafety Risk Group: | RG1 (check the PHAC ePATHogen Risk Group Database for updates) |
| Regulatory Requirements: | No restrictions for Canadian requesters. International requesters must provide all legally required importation documentation prior to shipment. Plant pathogenicity status may be verified by using the USDA Agricultural Research Service (ARS) Fungal Database |
| MycoBank ID: | 308822 |
| Sequences: | >UAMH05704_UAMH_ITS CATTACAGTGGAAGCGTCNAGCCGCGCATCCCCCCCCCGCGGGGGGGGGGAGCCCGCGGCCCGTACCTCACCACCCTTGTCTACCGAACCAATGTTGCCTTGGCAGGCCTGCCGCTCGCGGCTGCCGGGGGTCGCCGCGCAGGCGCCCCGGGCTCGCGCCTGCCANAGGAGCCTTTGAACTCGATCTGAANAACTGTCAGTCTGAGCGTAACAGCAAGAATCAAACAAAACTTTCAACAACGGATCTCTTGGTTCCGGCATCGATGAAAAACGCANCGAAATGCGATAAGTAATGTGAATTGCANAATTCCGTGAATCATCGAATCTTTGAACGCACATTGCGCCCTCTGGTATTCCGGGGGGCATGCCTGTTCGAGCGTCATTGCAAACCCCTCAAGCCCGGCTTGTGAGTTGGACCATCGTCCCCGCCCGTGCGGACGGGTCCNAAATGCAGTGTCGGCGCCNAGCTCCTGGTGTCTGAGTGTATGGGATCACTTCATCGCTCTTAAGACTCCGATCGGCGCCCGTCNAAACCCATATTCNTCCGGTT >UAMH05704_AJ315175_SSU ATGCATGTCTAAGTATAAGCAATTTGTACTGTGAAACTGCGAATGGCTCATTAAATCAGTTATCGTTTATTTGATAGTACCTTCAACTACATGGATACCCGTGGTAATTCTAGAGCTAATACATGCTAAAAACCTCGACTTCGGAAGGGGTGTATTTATTAGATAAAAAACCAATGCCCTTCGGGGCTCCTTGGTGATTCATAATAACTTGTCGAATCGCATGGCCTTGCGCTGGCGATGGTTCATTCAAATTTCTGCCCTATCAACTTTCGATGGTAGGATAGTGGCCTACCATGGTGGCAACGGGTAACGGGGAATTAGGGTTCGATTCCGGAGAGGGAGCCTGAGAAACGGCTACCACATCCAAGGAAGGCAGCAGGCGCGCAAATTACCCAATCCCGATACGGGGAGGTAGTGACAATAAATACTGATACAGGGCTCTTTCGGGTCTTGTAATCGGAATGAGAACAATTTAAATCCCTTAACGAGGAACAATTGGAGGGCAAGTCTGGTGCCAGCAGCCGCGGTAATTCCAGCTCCAATAGCGTATATTAAAGTTGTTGCAGTTAAAAAGCTCGTAGTTGAACCTTGGGTCTGGCTGGCCGGTCCGCTTCGCGGCGTGCACTGGTCCGGCTGGACCTTTCCTTCTGGGGAATCCTATGGCCTTCACTGGCTGTAGGGGGAACCAGGACTTTTACTGTGAAAAAATTAGAGTGTTCAAAGCAGCCTTTGCTCGGATACATTACATGGAATAATAGAATAGGACGTGTGGTTCTATTTTGTTGGCTTCTAGGACCGCCGTAATGATTAATAGGGATAGTCGGGGGCGTCAGTATTCGGCTGTCAGAGGTGAAATTCTTGGATTTGCTGAAGACTAACTACTGCGAAAGCATCGCCAAGGATGTTTTCATTAATCAAGAACGAAAGTTAGGGGATCGAAGACGATCAGATACCGTCGTAGTCTTAACCATAAACTATGCCGACTAGGGATCGGACGGGCAATTTTGAATAACCCGTTCGGCACCTTACGAGAAATCAAAGTTTTTGGGTTCTGGGGGGAGTATGGTCGCAAGGCTGAAACTTAAAGAAATTGACGGAAGGGCACCACCAGGCGTGGAGCCTGCGGCTTAATTTGACTCAACACGGGGAAACTCACCAGGTCCAACAAATAAGGATTGACAGATTGAGAGCTCTTTCTTGATCTTTTGGATGGTGGTGCATGGCCGTTCTTAGTTGGTGGAGTGATTTGTCTGCTTAATTGCGATAACGAACGAGACCTTAACCTGCTAAATAGCCCGACCCACATTTGTGGGCCGCTGGCTTCTTAGAGGGACTATCGGCTCAAGCCGATGGAAGTTTGAGGCAATAACAGGTCTGTGATGCCCTTAGATGTTCTGGGCCGCACGCGCGCTACACTGACAGGGCCAGCGAGTACATCACCTTGGCCGAGAGGTCTGGGTAATCTTGTTAAACCCTGTCGTGCTGGGGATAGAGCATTGCAATTATTGCTCTTCAACGAGGAATGCCTAGTAGGCACAAGTCATCAGCTTGTGCCGATTACGTCCCTGCCCTTTGTACACACCGCCCGTCGCTACTACCGATTGAATGGCTTAGTGAGGCCTTCGGACTGGCTCAGGGAGGTTGGCAACGACCACCCAGAGCCGGAAGTTGGCAAACTTGGCATTAGAGGAA |
IMAGES: